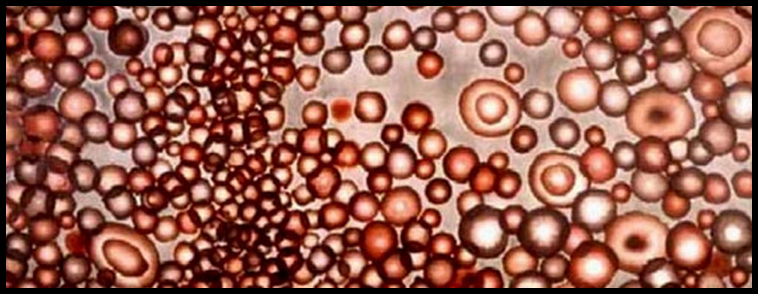

ความกลมกลืน (Harmony)
โดยทั่วไป หมายถึงการประสานเข้าสนิทกัน กลมกลืน ปรองดอง สามัคคี ลงรอย ในทางทัศนศิลป์ ความกลมกลืน หมายถึง การรวมกันของ หน่วยย่อยต่าง ๆ ซึ่งได้แก่ส่วนประกอบมูลฐาน ของศิลปะ คือได้แก่ จุด เส้น รูปร่าง รูปทรง สี พื้นผิว น้ำหนัก อย่างใดอย่างหนึ่งหรือหลายอย่าง และการจัดวางองค์ประกอบ เช่นจ้ังหวะ ช่องว่าง
ทำให้เกิดเป็นการประสานเข้า กันได้อย่างสนิท โดยไม่มีความขัดแย้ง ทำให้ผลงานการออกแบบ ทัศนศิลป์ มีความเป็นอันหนึ่งอันเดียวกัน หรือความมีเอกภาพ แต่อย่างไรก็ตาม ความกลมกลืนถ้ามีมากเกินไป ก็อาจจะ ทำให้ผลงานนั้นอาจดูน่าเบื่อได้ จึงต้องมีการ เพิ่มการขัดแย้ง หรือ ความแตกต่าง (Contrast) เข้าไปร่วมบ้างเพียงเล็กน้อย ก็จะให้ผลที่น่าสนใจขึ้น (ศึกษาในบทเรียนที่ 3.7 ความขัดแย้ง)
ประโยชน์อีกลักษณะหนึ่ง ของความกลมกลืนที่มีต่องานออกแบบทัศนศิลป์ ก็คือ การใช้ความกลมกลืนเป็นตัวกลางหรือตัวประสาน (Transition) ทำสิ่งที่มีความขัดแย้งกัน หรือสิ่งที่มีความแตกต่างกัน ให้อยู่ร่วมกันได้ เช่นสีดำ กับสีขาว เป็นน้ำหนักที่ตัดกันอย่างรุนแรง มีความขัดแย้ง กันอย่างสิ้นเชิง ก็ใช้น้ำหนักเทา หรือ น้ำหนักอ่อนแก่ระหว่างขาว ดำ มาเป็นตัวประสาน ให้สีดำ และสีขาวนั้นมีความกลมกลืนกัน

การใช้น้ำหนักเทา (ขวา) เป็นตัวประสานให้สีดำขาว (ซ้าย) ลดความขัดแย้งลง

หากเพิ่มค่าน้ำหนักตัวประสาน (สีเทา) ให้มีหลายค่า มากขึ้น ความกลมกลืนก็จะยิ่งเด่นชัดขึ้น

สีแดงและสีเขียว เป็นสีที่ตัดกันอย่างแท้จริง (True Contrast) มีความแตกต่าง กันอย่างรุนแรง (ซ้าย) หากเพิ่มน้ำหนักสีดำ (ขวา)เข้าไปเป็นตัวประสาน ทำให้ความรุนแรงนั้น ลดลง มีความกลมกลืนเกิดขึ้น

เส้นตั้งและเส้นนอนที่วางตั้งฉากกัน (ซ้าย) เป็นทิศทางของเส้นที่ขัดแย้งกัน อย่างรุนแรง หากเพิ่เส้นโค้งเข้าไปเป็นตัวประสาน (ขวา) ทำให้ความขัดแย้ง ลดลง เกิดความกลมกลืนขึ้นมาทันที

การสร้างความกลมกลืนในงานออกแบบทัศนศิลป์ มี 2 แนวทาง คือ 1. การสร้างความกลมกลืนทางด้านโครงสร้าง 2 . การสร้างความกลมกลืนทางด้านรูปแบบและแนวคิด
1. การสร้างความกลมกลืนทางด้านโครงสร้าง
หมายถึง ความกลมกลืน ที่เกิดจากส่วนประกอบมูลฐาน และ องค์ประกอบ หรือหลักการทัศนศิลป์ มีแนวทาง ดังต่อไปนี้ ความกลมกลืนด้วยเส้น


เส้นที่มีลักษณะและทิศทางเหมือนกันย่อมกลมกลืนกัน
ความกลมกลืนด้วยรูปร่าง

รูปร่างที่มีลักษณะเหมือนกันหรือคล้ายคลึงกันย่อมกลมกลืนกัน
ความกลมกลืนด้วยลักษณะผิว


ลักษณะผืวที่มีลักษณะเหมือนกันหรือคล้ายคลึงกันย่อมกลมกลืนกัน
ความกลมกลืนด้วยน้ำหนักอ่อน แก่

ค่าน้ำหนักอ่อน แก่ หรือ น้ำหนักของแสงเงาที่ไม่ตัดกันรุนแรง บนพื้นผิวที่นิ่มนวล ให้ความรู้สึก ประสานกลมกลืนกันได้ดี
ความกลมกลืนด้วยจังหวะกับบริเวณว่าง

การเว้นระยะของบริเวณว่าง (Space) ระหว่าง รูป (Figure) และพื้น (Ground)
ให้มีจังหวะเท่ากัน สม่ำเสมอ ทำให้เกิดความกลมกลืน
ความกลมกลืนด้วยสี

2. การสร้างความกลมกลืนทางด้านรูปแบบและแนวคิด
หมายถึง ความกลมกลืน ที่เกิดจากเรื่องราวเนื้อหา ที่ปรากฎในงาน ออกแบบทัศนศิลป์ มีความสัมพันธ์เป็นอันหนึ่งอันเดียวกันอย่างเด่นชัด ทั้งนี้ รวมถึงผลงาน ที่มีรูปแบบ แนวคิดที่เป็นแบบอย่างเฉพาะของ แต่ละ บุคคล ลัทธิ เชื้อชาติ ศาสนา เป็นต้น แม้ว่าผลงานเหล่านั้น อาจจะจะมีโครงสร้างที่ไม่กลมกลืนกันก็ตาม

ภาพจิตรกรรมลัทธิRomanticsm (บน) และลัทธิ Sur - Realism (ล่าง) นอกจากจะมีความประสานกันของ
น้ำหนัก สี และทิศทางของเส้นแล้ว ยังมีความกลมกลืนเป็นอันหนึ่งอันเดียวกันของแนวคิดการสร้างสรรค์ อีกด้วย
ขอบคุณเว็บไซต์
http://watkadarin.com/E-(new)1/02studio2classrm/unit3/chapt3.8harmony/harmony.htm
 |